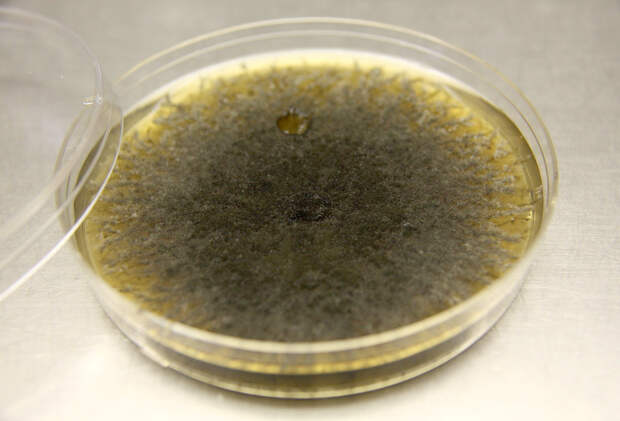

Как избавиться от грибка в квартире на стене: Как избавиться от грибка на стенах
Как убрать плесень со стены в квартире, фото / Неприятный запах спор грибка в комнате, видео
Плесневый грибок – один из самых неприятных паразитов, которые могут поселиться в квартире. От него темнеют и отваливаются обои, начинает отходить краска, а дерево просто начинает гнить изнутри. Скорость, с которой размножается грибок, просто огромна: буквально за месяц маленькое темное пятнышко может расползтись на всю комнату.
1 Как избавиться от грибка на стенах: подготовка помещение
2 Удаляем грибок со стен
3 Как убрать плесень со стен народными средствами
Но появление плесени неприятно не только с точки зрения эстетики. Наибольший вред грибок причиняет здоровью живущих в квартире людей. Не стоит удивляться, если здоровые люди, в квартирах которых завелась плесень, начинают постоянно болеть: такой сосед, как плесень, значительно ослабляет здоровье.
- Споры плесени токсичны для человека, особенно при вдыхании. Они раздражают нос, горло, легкие, вызывают кашель и служат причиной хронических легочных заболеваний, а если прожить бок о бок с раздражителем долгое время, то и астму.
 Кроме того, плесень вытягивает из воздуха кислород, делая воздух спертым и затрудняя дыхание;
Кроме того, плесень вытягивает из воздуха кислород, делая воздух спертым и затрудняя дыхание; - Еще неприятнее, если плесень появилась в кухне или столовой, рядом с продуктами питания. Токсины, которые выделяются грибком и спорами, попадают в организм, постепенно накапливаясь в печени и вызывая ее поражение;
- Споры, попадающие на кожу, провоцируют раздражение: дерматиты и аллергии различного характера. Споры, попавшие в глаза и нос, вызывают чихание, насморк и конъюнктивит.
Чем слабее иммунитет человека, тем больший вред причинит ему грибок. Некоторые люди годами могут жить с плесенью на стенах и не болеть, но стоит им немного простудиться или ослабеть, как грибок возьмет свое.
Но если пятно от плесени заметно, это полбеды. Часто в квартире просто из ниоткуда появляется неприятный затхлый или плесневый запах. Он заполняет вся квартиру, пропитывает вещи, и избавиться от него практически невозможно. Чаще всего запах говорит о том, что грибок завелся под обоями, под полом или в вентиляции, и для борьбы с плесенью придется напрячь все силы.
Прежде всего, нужно определить источник запаха. Чтобы это сделать, надо хорошо проветрить квартиру, а затем закрыть в ней все двери. В какой комнате запах появится раньше всего – там и нужно искать. Найти источник запаха в комнате можно также: хорошо проветрить и походить по комнате, принюхиваясь, откуда начинает пахнуть и где запах сильнее всего. Грибок любит селиться там, где почти нет движения воздуха: за шкафами, под полом, под обоями. Если есть возможность, то шкафы следует отодвинуть, картины и фотографии снять, ковры приподнять или скатать. Когда источник неприятного запаха найден, можно планировать, как избавиться от плесени.
Как избавиться от грибка на стенах: подготовка помещение
Прежде всего, нужно выяснить, как плесень попала в жилище. Плесневые споры не редкость, но чтобы укорениться и разрастись, им нужны пригодные для жизни условия. При повышенной влажности в квартире, промерзающих стенах или неработающей вентиляции появление грибка – дело времени.
Перед началом ремонта стоит привести подготовительные работы. Если в доме постоянно течет кран, или стоит незакрытый аквариум, или соседи сверху регулярно устраивают потоп и стены не успевают высохнуть – нужно сначала устранить причины сырости. Это же относится к плохой вентиляции. В большинстве современных квартир стоят пластиковые окна, которые плотно закрываются и через которые в квартиру почти не попадает свежий воздух. Зимой на них часто образуется конденсат – первый признак высокой влажности и плохой вентиляции квартиры.
Если в доме постоянно течет кран, или стоит незакрытый аквариум, или соседи сверху регулярно устраивают потоп и стены не успевают высохнуть – нужно сначала устранить причины сырости. Это же относится к плохой вентиляции. В большинстве современных квартир стоят пластиковые окна, которые плотно закрываются и через которые в квартиру почти не попадает свежий воздух. Зимой на них часто образуется конденсат – первый признак высокой влажности и плохой вентиляции квартиры.
Если после принятия ванной или душа конденсат на стенах не высыхает дольше получаса, это повод обратиться в домоуправление с просьбой прочистить вытяжку. Если на окнах зимой наледь и капли воды, это повод установить дополнительную вентиляцию. Когда в квартире станет сухо, избавиться от плесени будет гораздо проще.
И только устранив причину появления плесени и создав для грибка неблагоприятные условия, можно переходить непосредственно к уничтожению паразита.
Удаляем грибок со стен
Средство от плесени на стенах лучше выбрать профессиональное. Лучше всего убрать плесень со стен помогают специальные магазинные антигрибковые средства. Купить их можно в строительном или хозяйственном магазине.
Лучше всего убрать плесень со стен помогают специальные магазинные антигрибковые средства. Купить их можно в строительном или хозяйственном магазине.
Также понадобятся:
- Антигрибковая пропитка и антигрибковая грунтовка для стен, желательно глубокого проникновения, а так же гидроизолирующее покрытие для стен;
- Респиратор с хорошим фильтром и строительные очки. Марлевой повязки, прикрывающей рот, не хватит, чтобы защитить легкие от спор и строительной пыли;
- Шпатели или подобный инструмент для удаления со стен старого покрытия;
- Плотные мешки для мусора;
- Желательно, но не обязательно – строительный фен или паяльная лампа. Без этих приборов можно обойтись, но ремонт продлится дольше.
Первое, что нужно сделать для удаления плесени со стен – удалить ее в буквальном смысле. Пораженную грибком поверхность нужно полностью очистить, содрав обои или удалив побелку. Так как расползается плесень незаметно, нужно зачистить все в радиусе полуметра от темного пятна. Часто у хозяев возникает вопрос: надо ли снимать обои или смывать краску во всей комнате. Это не обязательно, если поражение небольшое. Если плесень завелась в углу комнаты, то нужно очистить обе стены, а если грибок завелся по центру одной стены, то очищать всю комнату не нужно.
Часто у хозяев возникает вопрос: надо ли снимать обои или смывать краску во всей комнате. Это не обязательно, если поражение небольшое. Если плесень завелась в углу комнаты, то нужно очистить обе стены, а если грибок завелся по центру одной стены, то очищать всю комнату не нужно.
Все работы нужно производить в респираторе, чтобы не наглотаться разлетающихся спор и строительной пыли. Так же необходимы очки, которые защитят глаза.
Сорванные обои и счищенную побелку нужно как можно быстрее упаковать в мешок для мусора (а лучше в несколько) и выкинуть. Это делается потому, что споры грибка разлетаются от малейшего движения и дуновения ветра, поэтому не стоит рисковать и разносить заразу дальше. Если заражение серьезное, а атмосфера в квартире по-прежнему благоприятствует грибку, стоит заодно выкинуть или стерилизовать шпатели, которые соприкасались с грибком и сменить перчатки и респиратор.
Очищенные стены следует высушить. Как правило, на это уходи несколько суток, но с помощью паяльной лампы или строительного фена сделать это можно намного быстрее. Горячий воздух еще и очень хорошо убивает оставшийся грибок, который плохо переносит такие высокие температуры.
Горячий воздух еще и очень хорошо убивает оставшийся грибок, который плохо переносит такие высокие температуры.
На полностью сухую стену наносится антигрибковая пропитка, антисептик. После того, как пропитка высохнет полностью (как правило, через несколько часов), стена обрабатывается еще раз, в 2-3 слоя. Только тогда можно быть уверенным, что грибок погиб.
На высохшую пропитку кладется грунтовка, которая препятствует возвращению грибка.
Грунтовка еще раз покрывается антисептиком и гидроизолирующим покрытием, которым нельзя пренебрегать в сырых помещениях. Когда все слои полностью высохнут, можно снова клеить обои, класть плитку или красить восстановленную стену.
Как убрать плесень со стен народными средствами
Народные средства, которые часто предлагают использовать против грибка, не настолько надежны, как магазинный антисептик. Считается, что многие из них более безопасны для человека, и это действительно так, но и на грибок они действуют гораздо слабее и не гарантируют результата.
Например, сода, которой рекомендуют бороться с грибком, помогает мало. Она удаляет загрязнения, отбеливает темные пятна и убирает неприятный запах, почти ничего не может сделать с грибком.
Нашатырный спирт и перекись водорода обладают выраженным асептическим эффектом и продаются в любой аптеке. Перекись используют в чистом виде (3% или 5% раствор), а нашатырь разводят в стакане воды в пропорции 1:1. Работать с нашатырем нужно очень аккуратно, в открытом, проветриваемом помещении, не снимая респиратора, чтобы не отравиться парами этого едкого вещества. Такие же методы предосторожности применяются при работе с хлором или отбеливателем на основе хлора, и уксусом. Эти резко пахнущие вещества хоть и помогут очистить стены от плесени и удалят неприятный затхлый запах, но пахнуть в квартире этими средствами будет еще несколько дней.
Почти не помогает убрать плесень со стен масло чайного дерева. Оно освежит воздух, уберет неприятный запах и замедлит рост грибка, но полностью побороть его не сможет, несмотря на свои антибактериальные свойства. На масло плохо ложатся все последующие покрытия, включая грунтовку, поэтому использовать это средство для борьбы с плесенью нужно аккуратно.
На масло плохо ложатся все последующие покрытия, включая грунтовку, поэтому использовать это средство для борьбы с плесенью нужно аккуратно.
Появление в квартире неприятного запаха – тревожный симптом. Разрушение дома и здоровья жильцов может идти медленно и незаметно, и если ничего не делать для борьбы с плесенью, то этот паразит постепенно захватит весь дом и отравит живущих в нем людей. Чтобы избежать повторного появления плесени, нужно регулярно проветривать ванную комнату, следить за состояние окон, и принимать меры при малейших признаках сырости. Даже обработка стен самым дорогим средством не даст гарантии, что грибок не вернется снова, если в квартире не поддерживается нормальная влажность. Избавиться от плесени довольно сложно, а от запаха, который она вызывает – еще сложнее, но очистить дом и дышать чистым воздухом без спор гораздо приятнее и полезнее для здоровья.
🔶 Плесень на стенах в квартире ✔ как избавиться от плесени на стенах
Плесень – отложение микроскопических грибковых колоний, тело которых напоминает ветвящиеся стебли. Они видны невооружённым взглядом, поэтому не заметить их невозможно. Плесень на стенах очень опасна как для поверхности, на которой образуется, так и для здоровья человека. Мнение о том, что появляется грибок только в неухоженных, запущенных помещениях ошибочно.
Они видны невооружённым взглядом, поэтому не заметить их невозможно. Плесень на стенах очень опасна как для поверхности, на которой образуется, так и для здоровья человека. Мнение о том, что появляется грибок только в неухоженных, запущенных помещениях ошибочно.
Развиться она может и в добротном здании. Это поясняется тем, что заражение осуществляется спорами, которые могут переноситься разными способами: по воздуху или на носителях – например, оседая на шерсть животных или обувь.
плесень на стенеПочему появляется плесеньЕсть ряд факторов, способствующих развитию этого неприятного явления:
- Высокая влажность воздуха в помещении. Возникает из-за слишком частых влажных уборок или сушки стираного белья в доме.
- Наличие трещин в стеновых конструкциях. Получаются из-за того, что перед финишной отделкой хозяева пренебрегли подготовительными работами. В результате в микротрещинах начинают развитие микроспоры, которые потом заполоняют всю поверхность стенки.

- Конденсат на трубопроводе. Если трубы дома часто «потеют», а причина этого явления не выявлена, нужно вызвать мастеров, чтобы они нашли и устранили этот недочёт. В противном случае плесень на стенах обязательно появится и произойдёт это очень быстро.
- Засорение вентиляционной системы. Поскольку старые окна практически все поменяли на пластиковые, нужно позаботиться о дополнительной вентиляции квартиры. Если она уже организована, нужно следить за чистотой, своевременно прочищать. Иначе проблема не заставит себя долго ждать.
- Резкие, регулярные температурные перепады. Чаще всего это происходит из-за неправильно произведённого утепления. Этот недочёт тоже способен сыграть злую шутку с итоговым развитием плесени в доме. Особенно при наступлении первых заморозков.
Первые признаки того, что грибок уже развился в квартире:
- специфически-неприятный острый запах;
- появление мокроты на стенах в квартире;
- преобразование влажного пятна в серый, чёрный или белёсый цвет.

Эти симптомы говорят о том, что непрошеная «гостья» уже поселилась в жилище. Откладывать уничтожение в долгий ящик ни в коем случае нельзя. Плесень быстро распространяется и спустя некоторое время заполонит всю стеновую поверхность или большую её часть.
Важно! Проблему следует решать комплексно, поскольку простого физического уничтожения будет недостаточно. Этим действием вы уничтожите только верхушку проблемы, корень останется на заражённой поверхности.
Виды плесениГрибок бывает разным, вид зависит от материала, на котором проявился:
- Плесневой. Селится на поверхности из монолита или камня. Имеет вид пятен различных размеров или точек. Оттенок, характерный этому виду плесени: бурый, голубой, чёрный или зелёный. Иногда может быть светящимся, флуоресцентным. Плесневый грибок опасен тем, что способен полностью разрушать поверхности, которые заражает. Если вовремя не избавиться, очень скоро придётся делать ремонт в квартире, причём не косметический, а капитальный.

- Синева. Частые места обитания – древесные конструкции. Узнать, что плесень уже появилась, очень просто – заражённые зоны приобретают серо-синий оттенок. Простое покрытие поверхности краской проблему не решит. В древесине, вследствие разрушения её грибком, обязательно появятся каналы, через которые проникнет влага. Дерево разбухнет, образуя идеальные условия для жизнедеятельности и размножения грибка.
- Гниение. Плесень этого типа именуется гнилью. Очаги заражения приобретают бурый или белый цвет. Грибок напрочь разрушает целлюлозу и лигнин. Обе эти составляющие содержит древесина. Если пол в квартире и стены состоят из этого материала, то уже за месяц будут полностью разрушены, после чего плесень распространится на другие деревянные поверхности, в частности – мебель.
Интересный факт! В старину дома из дерева, заражённые гнилью, сжигались. Это происходило потому, что их хозяева не знали, как избавиться от этой заразы.
Разновидности по цвету, степень опасности каждой:
- Зелёная (травяная).
 Встречается часто. Бояться её не нужно, она быстро удаляется с обоев.
Встречается часто. Бояться её не нужно, она быстро удаляется с обоев. - Темно-зелёная (болотная). Удаление – сложней и проблематично. Но если сразу приступить к борьбе, можно полностью извести.
- Белая (молочная), напоминающая пух. Распространяется практически незаметно. Всё помещение поражает в максимально сжатые сроки. С этим видом заражения медлить категорически нельзя. Кроме быстрого распространения, очень опасен для здоровья человека. Снимать её и бороться с остатками следует осторожно. Настоятельно рекомендуется производить эту процедуры в респираторе и защитных перчатках. Часто встречается в цветочных горшках, на мебели, деревянных поверхностях.
- Синева. Распространённые зоны поражения – подоконники, паркет, двери и прочие древесные конструкции.
- Бурая. Любит «селиться» на деревянных изделиях. Губительно воздействует на материал, трудно изводится.
- Чёрная. Вызывает глобальные разрушения поверхностей, которые поразила.
 Считается самой опасной из представленных. Стремительно распространяется, выводится трудно. Появиться может везде: кафель, обои, потолок, стены.
Считается самой опасной из представленных. Стремительно распространяется, выводится трудно. Появиться может везде: кафель, обои, потолок, стены.
Важный факт! Заражённые чёрной плесенью поверхности придётся обрабатывать особыми химическими составами. После обработки регулярно производится профилактика, потому что эта разновидность может возродиться снова. Опасны споры этой гнили и для человеческого здоровья, поскольку, попадая в организм, вызывают нарушения метаболизма (обмена веществ) на клеточном уровне, что приводит к серьёзным патологическим изменениям. Существенно понижают защитные функции, а значит, человек начнёт болеть чаще прежнего.
Чем опасна плесеньЭто грибковое образование выделяет споры, которые распространяются по воздуху, а значит, легко попадают в организм через дыхательную систему, принося существенный урон здоровью. Проанализируем самые распространённые типы влияния чёрной плесени на стенах, поскольку она самая опасная:
- Сырость.
 Считается катализатором самых распространённых болезней верхних дыхательных путей: ринит (насморк), ларингит, бронхит, синусит и даже пневмония. При постоянном нахождении в сыром помещении может развиться бронхиальная астма.
Считается катализатором самых распространённых болезней верхних дыхательных путей: ринит (насморк), ларингит, бронхит, синусит и даже пневмония. При постоянном нахождении в сыром помещении может развиться бронхиальная астма. - Микроорганизмы. Бактерии, выделяемые плесенью, часто становятся причиной развития кожных патологий: дерматозы, микозы, экземы, дерматиты и даже псориаз.
- Грибковая спора. Относятся к категории сильнейших аллергенов. Проникая внутрь организма, особенно людей с повышенной реакцией, способны вызывать серьёзные осложнения аллергии, конъюнктивита, аллергодерматоза.
- Грибок из ванной. Оседая на предметы личной гигиены, часто вызывает развитие стоматитов, кандидоза.
- Квартирная плесень. Проникает внутрь человеческого организма и с продуктами питания. Накапливаясь там, может спровоцировать патологию в почках или развитие цирроза печени.
- Токсины. Множество видов токсинов, с включением в этот список грибковых спор, способно вызывать у жителей заражённой квартиры пищевой микотоксикоз.
 Эта патология опасна сопутствующей симптоматикой. А именно: тошнотой, рвотой, расстройствами кишечника, сильными болями в животе, потерей аппетита. Они же губительно воздействуют на нервную и сердечно-сосудистую системы. Становятся причиной нарушения сна.
Эта патология опасна сопутствующей симптоматикой. А именно: тошнотой, рвотой, расстройствами кишечника, сильными болями в животе, потерей аппетита. Они же губительно воздействуют на нервную и сердечно-сосудистую системы. Становятся причиной нарушения сна. - Продукты жизнедеятельности грибков – афлатоксины. Вызывают опасный альфатоксикоз. Накапливаясь в организме, становится причиной мутации клеток, что приводит к развитию раковых новообразований. Альфатоксикоз смертельно опасен для детей. Так как их организм ещё очень слаб, болезнь может стать причиной смерти.
Это неполный, но основной список опасных факторов, вызванных спорами плесени.
Как убрать плесень в домашних условияхИзбавляться от грибкового заражения стен в квартире следует комплексно, подходить к процедуре ответственно и серьёзно. Нельзя недооценивать плесень, ведь это живой организм, который растёт, развивается, размножается, принося урон здоровью человека и самим поверхностям. Единого регламента самостоятельной борьбы нет. Поэтому дезинфекция грибка в квартире проходит с использованием нескольких средств.
Единого регламента самостоятельной борьбы нет. Поэтому дезинфекция грибка в квартире проходит с использованием нескольких средств.
Ключевые моменты:
- Регулярное проветривание жилища.
- Обработка поражённых зон качественными антисептиками.
- Гидроизоляция поверхностей, на которых появился грибок.
Если он проявился на обоях, то лучше совсем от них избавиться. Просто пройтись тряпкой с дезинфицирующим средством – недостаточно. Арсенал домовладельца:
- Специальные, профессиональные средства на химической основе.
- Сподручные народные средства.
Нужно понимать, что извести плесень на стене в квартире удастся, если своевременно начать эту борьбу, иметь под рукой хорошие средства, соблюдать последовательность выполнения процедуры.
Регламент уничтожения грибка чёрной плесени с сильно заражённых участков:
- Тщательно просушить поверхность стен, пола, потолка, используя строительный фен, тепловентилятор.
- Убрать обои, керамику или другое покрытие с заражённой стены, используя шпатель.
 Это нужно обязательно сделать, потому что под ними могут находиться споры, которые потом спровоцируют новую вспышку заражения.
Это нужно обязательно сделать, потому что под ними могут находиться споры, которые потом спровоцируют новую вспышку заражения. - Обработать стены в квартире растворами бактерицидной группы глубокого проникновения, широкого спектра действия. Предназначенными специально для борьбы с плесенью.
- Прогрунтовать стеновые поверхности в квартире специальным акриловым грунтом.
- Обработать гидроизоляционным составом для предупреждения попадания влаги в щели штукатурки. После высыхания первого пласта следует нанести сверху ещё один слой гидроизоляции, используя антисептический грунт.
- Для верности, в плане выведения грибка, рекомендуется следующим шагом произвести нанесение слоя штукатурки. После её высыхания сверху покрыть шаром теплоизоляционной краски.
Только произведя все эти 6 действий, можно будет приступить к финишной отделке – поклейке обоев, покраске стен в квартире.
Химические средства, признанные наиболее эффективными в борьбе плесенью:
- Neomid Bio (Неомид Био).

- Mogel-Fri.
- Олимп Стоп плесень.
- Дали.
- Метас Био.
- Фонгифлюид.
Совет! Очень сложно извести грибок с деревянных конструкций и поверхностей. Заражение способно достаточно глубоко проникать внутрь, не проявляясь на протяжении какого-то периода. Но настанет время, когда оно проснётся. Чтобы полностью извести гниль, желательно полностью вырезать поражённые участки (желательно с захватом). Края срезов 2, а лучше 3 раза обработать антисептиком.
Из народных средств стены в квартире можно обрабатывать:
- Уксус. Столовый уксус не разводят, наносят таким, какой есть. Равномерно покрыть пятно, подождать час, затем смыть водой, дать стенке просохнуть.
- Перекись водорода. Эффективна, если зона поражения не слишком велика. Схема действий аналогична. Концентрация – 3% раствор.
- Фурацилин. На 200 гр. воды надо задействовать 15 растолчённых в порошок таблеток. Раствор нанести на «больную» поверхность.
 Перед очисткой тщательно просушить строительным феном или бытовым обогревателем.
Перед очисткой тщательно просушить строительным феном или бытовым обогревателем. - Белизна. Состав содержит гипохлорит натрия. Это вещество губительно воздействует на живой грибок. Средство эффективно работает на твёрдых плоскостях. Раствор готовится в пропорции вода-белизна из расчёта 10:1 соответственно. После высыхания первого слоя нужно будет проделать процедуру повторно.
- Хозяйственное мыло. Мыльным раствором (измельчённый брусок, замочить в воде, дать сутки отстояться), обрабатывать можно «больное» дерево. После высыхания остатки удалить тряпкой.
- Медный купорос. Эффективно против чёрной плесени работает именно это вещество. Готовят средство так: берётся примерно 100 гр. порошка, разводится в ведре на 10 л воды. С помощью бытового распылителя обрабатывают стены квартиры. Если приспособления дома нет, можно проделать процедуру нанесения обычной щёткой.
Совет! Нежелательно применять медный купорос, если впоследствии запланирована поклейка обоев. Средство после себя на стенках оставляет налёт отчётливого голубого цвета.
Средство после себя на стенках оставляет налёт отчётливого голубого цвета.
Чтобы избавить себя от хлопот и тяжёлых процедур избавления от плесени на стенах квартиры, нужно проводить профилактические мероприятия. Особенно если гниль уже проявлялась ранее, или жилище относится к категории риска. Меры, которые обязательно нужно проделать после утомительного и весьма тяжёлого избавления от плесени на стенах квартиры:
- часто проветривать жильё;
- в дневное время открывать шторы на окне – естественное освещение убивает грибок;
- не прислонять предметы мебели очень плотно к стеновой поверхности;
- организовать функционирующую систему вентиляции в ванной и кухонной комнатах;
- численность цветочных горшков сократить, частый полив растений увеличивает влажность воздуха;
- не сушить стирку в квартире;
- избавить от плесени в ванной поможет установка полотенцесушителя;
- раз в 30 дней обрабатывать стенки противогрибковым средством.

Эти простые действия предупредят развитие опасной для здоровья человека и дома «болезни» под названием – плесень. Нелишним будет и зрительное исследование: беглый визуальный осмотр стен и потолка в квартире, которые удалось избавить от нашествия грибка.
Как вывести плесень на стенах в квартире
- Откуда берется плесень?
- Как вывести грибок со стен?
- Как убрать плесень со стен специальными средствами?
- Как вывести плесень на стенах народными средствами?
- Полезные советы
- Стоковая видеозапись
Плесень – хороший знак только на дорогом сыре определенных сортов, но не на поверхностях вашего дома. Как убрать плесень на стенах в квартире, если она появилась внезапно и не поддается чистке, надо знать. Его просто необходимо удалить, так как он вреден для здоровья, а появившись на одном месте небольшим островком, грибок быстро распространится по всей квартире.
к содержанию ↑
Откуда появляется плесень?
Прежде чем убрать грибок на стенах, нужно определить, почему он возник. Учтите, что если проигнорировать этот нюанс, после очистки одной поверхности плесень запросто может возникнуть в другом месте. Поэтому выясните и нейтрализуйте причину его возникновения, и только потом приступайте к работе.
Учтите, что если проигнорировать этот нюанс, после очистки одной поверхности плесень запросто может возникнуть в другом месте. Поэтому выясните и нейтрализуйте причину его возникновения, и только потом приступайте к работе.
Причины появления плесени:
- Повышенная влажность в помещении.
- Плохая вентиляция или ее полное отсутствие.
- Некачественная установка окон.
- Нарушенная герметичность межпанельных швов.
к оглавлению ↑
Как вывести грибок со стен?
Существует большое количество средств для удаления плесени с поверхностей. Они бывают как химические, так и натуральные, которые есть в каждом доме. В зависимости от того, каким методом вы будете уничтожать грибок, вам могут понадобиться такие средства:
- «Очиститель ArmMix»;
- «Антисептик АрмМикс»;
- «АрмМикс Универсал»;
- «АрмМикс — защита от грибка и сырости»;
- «Магнитерм»;
- клей канцелярский;
- перекись водорода;
- уксус;
- купорос;
- отбеливатели хлорные;
- аммиак.

Вам также потребуются такие вспомогательные инструменты:
- шпатели; краскопульт
- ; наждачная бумага
- ;
- емкость для смешивания растворов; ролик
- ;
- кисти.
Примечание: Если вы сторонник химической обработки, обязательно приобретите все необходимое в хозяйственных магазинах. Помимо средств, вам понадобится респиратор и резиновые перчатки, так как работа с химическими веществами обязательна в защитной одежде.
к оглавлению ↑
Как убрать плесень со стен специальными средствами?
Плесень размножается спорами и делает это очень быстро, поэтому важно удалять ее на ранних стадиях. Когда вы заметили лишь маленькое пятнышко, уже следует принимать меры. Но часто бывает так, что под обоями развивается плесень и когда она становится видна, то к тому времени она уже прилично разрастается. О том, как убрать плесень с обоев, вопросов не возникает – избавляться от них нужно как можно быстрее.
При использовании химических, профессиональных средств работа разбивается на несколько этапов и занимает несколько дней.
Этап 1
На этом этапе используйте «Очиститель ArmMix». Снимая цементный слой, он открывает бетон для очистки. Используйте в следующей последовательности:
- Удалите все обои с плесенью, а также очистите обои примерно на 50 см.
- Возьмите шпатель и удалите слой штукатурки вместе с формой.
- Щеткой обработать место зачистки средством.
Этап 2
Следующий этап – антисептическая обработка стен. Таким образом, вы уничтожите грибок на поверхности. При решении вопроса, как вывести грибок на стенах в квартире, следуйте этой пошаговой инструкции:
- Dry ArmMix Антисептическая почва в воде, как указано производителем.
- С помощью валика нанесите раствор на стену.
- Подождите, пока изделие высохнет.
- Повторите процедуру еще два раза.
Примечание: средство способно уничтожить большое количество видов вредных бактерий и микроорганизмов, но оно токсично.
Работайте в специальной одежде и проветривайте помещение, чтобы как можно быстрее завершить процесс решения проблемы, как вывести плесень на стенах. Дети и беременные женщины не должны находиться в помещении в течение недели.
Этап 3
После дезинфекции стены используйте ArmMix Universal. Он предназначен для глубокой очистки стены и удаления оставшихся спор. Вот как он наносится:
- Возьмите чистый валик.
- Пропитать грунтовкой.
- Нанесите на весь периметр стены.
- Дать высохнуть.
Этап 4
Для предотвращения развития плесени в дальнейшем поверхность стены обработать гидроизоляционной смесью «АрмМикс — защита от грибка и сырости» и закрепить грунтовкой «АрмМикс Универсал». Инструкция:
- Используя подходящий инструмент, обработайте стену первым средством.
- Дайте высохнуть.
- Нанесите праймер на всю обрабатываемую область.
Этап 5
На завершающем этапе используйте любую штукатурку и теплоизоляционную краску «Магнитерм».
- Оштукатурить стену.
- Дождитесь полного высыхания.
- Нанесите краску и дайте ей высохнуть.
Примечание: После выполнения всех действий и получения качественного результата для решения задачи, как убрать плесень на стенах, можно приступать к декору стен. Покройте его обоями, краской или декоративной штукатуркой. В идеале именно так должны быть обработаны стены в каждом доме в процессе ремонта, если не следить за температурой и влажностью в помещении. Тогда грибок никогда не появится на ваших стенах. Но будьте осторожны — химикаты токсичны и могут нанести вред.
к оглавлению ↑
Как вывести плесень на стенах народными средствами?
Натуральные средства также могут удалить плесень со стен. Они не вредны и есть практически в каждом доме. Есть несколько способов их использования.
Примечание.
Перед использованием любого из следующих инструментов необходимо провести работы по очистке. Оформите его, придерживаясь четко такой схемы:
- Используйте любой твердый инструмент: металлическую щетку, наждачную бумагу или нож. Соскребите плесень.
- Утилизировать полученный материал.
- Протрите это место обычным моющим средством для посуды или полов.
После выполнения этой работы приступайте к использованию специнструмента.
Метод 1
Используйте обычный канцелярский клей следующим образом:
- Клей растворите в воде 1:1.
- Нанести на пораженный участок кистью.
- Дать высохнуть.
Метод 2
Перекись водорода справляется с небольшими участками повреждения. Если вы только что заметили грибок, который сильно не разросся, это средство вам очень подойдет. Применяется следующим образом:
- Не жалея, нанесите перекись на очищенное место.

- Вы можете повторить процедуру, чтобы закрепить результат.
Метод 3
Любой хлорсодержащий продукт обладает антисептическими свойствами и нейтрализует плесень. Посмотрите, что у вас есть в наличии, и с помощью хлорки или других средств решите вопрос, как и чем вывести грибок на стенах в квартире:
- Разбавьте продукт водой, где на 3 части воды — 1 часть продукта.
- Нанесите на нужные области.
- Подождите, пока он высохнет. Только тогда можно будет украшать.
Примечание: Не используйте неразбавленный продукт — в чистом виде вредно испарение.
Способ 4
При больших площадях распространения плесени хорошо подходят медный купорос и уксус. Следуйте этим рекомендациям, чтобы быстро завершить процесс и легко справиться с задачей, как убрать плесень со стен:
- Развести 0,5 кг продукта в 10 л воды.
- Добавить 3 ст. уксус.
- С помощью валика нанесите раствор на стену.

- Дайте высохнуть.
Метод 5
Подобно отбеливателю, аммиак воздействует на плесень. Он подходит только для непористых поверхностей и используется следующим образом:
- Смешайте нашатырный спирт и воду 1:1 и заполните пульверизатором.
- Распылите на пораженный участок.
- Убедитесь, что изделие высыхает в хорошо проветриваемом помещении.
к оглавлению ↑
Полезные советы
Для предотвращения появления и размножения грибка на стенах в квартире соблюдайте следующие рекомендации:
- Храните хорошо просушенную одежду в шкафах.
- Следите за количеством комнатных растений и их адекватным поливом.
- После душа не закрывайте плотно двери в ванную комнату и по возможности установите в этой комнате вентилятор. Используйте его после мытья рук и принятия ванны или душа.
- При очередном ремонте принять все необходимые меры для предотвращения появления грибка.

- Регулярно, не реже одного раза в 3 месяца, обращайте внимание на потолки, полы, стены и мебель. Это позволит вовремя обнаружить вредителя.
к оглавлению ↑
Видеоматериал
Теперь вы знаете, как убрать плесень на стенах в квартире, и мы надеемся, что следуя нашим советам, вы быстро решили проблему. В будущем постарайтесь ее предупредить, чтобы не тратить время на борьбу с грибками и не навредить себе и своим близким!
Плесень в шкафу? Вот как избавиться от него навсегда
Судорожный кашель, хроническая усталость и красные, зудящие глаза могут быть признаком скрытого виновника: плесени, растущей в вашем шкафу.
Токсичная черная плесень процветает в темных, влажных местах, выделяя споры, питаясь материалами, найденными в гипсокартоне, ковре, бумаге, картоне или ткани. Вдыхание этих спор может вызвать симптомы, которые вы можете принять за респираторную инфекцию или аллергию.
Более тяжелые случаи отравления плесенью могут включать тошноту, рвоту или кровотечение в легких и носу.
Вы знаете, как удалить плесень в шкафу?
Наши сертифицированные специалисты по уборке и реставрации ServiceMaster Chicago имеют многолетний опыт удаления плесени для местных домовладельцев.
От чердаков до подвалов и даже самых чистых чуланов — мы видели все это. Мы знаем, почему это происходит, и знаем, как это предотвратить.
Начнем.
Что вызывает плесень в шкафах?
Плесень не может расти без влаги, поэтому туалет с высокой влажностью или протечкой может стать благодатной средой для размножения спор плесени.
Три наиболее распространенных пути проникновения влаги и плесени в ваши шкафы:
1. Протекающая сантехника
Протекающие трубы за стенами могут быть скрытым источником влаги в вашем доме. Проблемы с сантехникой могут привести к тому, что в шкафу рядом с ванной или кухней может расти влага, необходимая для роста плесени.
2. Плесень для чердака
Протекающая крыша или влажность могут добавить влаги на чердак. Как только плесень начинает расти над головой, она может мигрировать через потолки шкафов и проникать в стены.
3. Влажность
Двери шкафа обычно остаются закрытыми, поэтому любая влага из воздуха может попасть туда. Это может быть проблемой летом, а также в регионах с высокой влажностью большую часть года.
Признаки плесени в шкафу
Респираторные симптомы, от которых вы не можете избавиться, усиливающиеся головные боли и затхлый запах в вашем доме — безошибочные признаки того, что в вашем доме есть плесень.
Вероятным виновником могут быть шкафы, потому что они обычно темные, с задними стенами и углами, которые трудно увидеть.
Иногда на стенах видны споры черной плесени, поэтому проверьте, пролили ли свет на стенки шкафа. Они также могут быть зелеными или белыми .
Опасна ли плесень в шкафу?
Плесень потенциально может вызвать серьезные проблемы со здоровьем, сообщает EPA. Их споры производят аллергены, раздражители и токсические вещества. Вдыхание или прикосновение к плесени или спорам плесени может вызвать аллергические реакции, такие как чихание, насморк, покраснение глаз, головные боли и кожная сыпь.
Их споры производят аллергены, раздражители и токсические вещества. Вдыхание или прикосновение к плесени или спорам плесени может вызвать аллергические реакции, такие как чихание, насморк, покраснение глаз, головные боли и кожная сыпь.
Более серьезные проблемы могут включать кровотечение в легких и носу. Плесень также может вызывать приступы астмы и другие респираторные заболевания. Маленькие дети, пожилые люди и люди с заболеваниями легких могут быть особенно чувствительны к плесени в доме.
Опасность плесени побудила Всемирную организацию здравоохранения признать ее опасной для здоровья.
Как удалить плесень в шкафу
Хотя избавиться от всей плесени и спор плесени в помещении невозможно — некоторые споры плесени всегда можно найти в воздухе и пыли в вашем доме — вы можете предпринять следующие шаги, чтобы уменьшить количество плесени в твой шкаф.
- Убедитесь, что помещение хорошо проветривается. Откройте окна и включите вентиляторы в этом районе.

- Накройте любую мебель или вещи (или уберите их из комнаты).
- Накройте тканью или пластиковым покрытием для защиты ковра или пола .
- Костюм : наденьте защитное снаряжение, чтобы плесень не попала на кожу, в глаза и не вдыхалась.
- Смочите форму. Этот шаг кажется нелогичным, но чтобы споры плесени не разлетались по комнате во время работы, ключевым моментом является небольшое количество влаги.
- Смешайте чистящий раствор , в соответствии с рекомендациями CDC и EPA, и соскребите плесень.
- Промойте (из пульверизатора) и тщательно
- В центре внимания защита от плесени . Поддерживайте низкую влажность, чтобы плесень не вернулась.
Имейте в виду, что это решение «сделай сам» не гарантирует, что вы полностью удалите плесень.
Компания по устранению плесени может иметь решающее значение не только для определения наличия плесени и ее удаления, но и для поиска источника влаги — в конце концов, EPA отмечает, что устранение плесени начинается с устранения влаги.
Проще говоря, если не решить проблему влажности в шкафу, плесень вернется.
Такой поставщик, как ServiceMaster Restoration by Zaba , проверит ваш дом, чтобы определить, нет ли протечки, которая вызывает рост плесени в вашем туалете.
Как удалить плесень с одежды или обуви
Можно удалить плесень с одежды и обуви, стирая с уксусом вместо моющего средства для удаления запаха или удаляя плесень снаружи щеткой перед стиркой с моющим средством в горячей воде и сушкой в солнце.
Из-за вредного воздействия на здоровье вам следует избегать воздействия плесени на себя или других. У профессиональных специалистов по удалению плесени есть необходимое оборудование, необходимое для безопасного удаления плесени.
Как предотвратить рост плесени в шкафах: 10 простых способов
Остановить плесень означает остановить влажность. Чтобы предотвратить попадание плесени в шкафы и их содержимое, Агентство по охране окружающей среды рекомендует поддерживать влажность в помещении ниже 60 процентов, а в идеале от 30 до 50 процентов .
Другие способы сохранить ваши туалеты сухими и без плесени включают:
Одежда должна быть на 100 % сухой перед тем, как положить ее в шкаф. Кроме того, не бросайте в корзину влажную одежду, так как это может задержать влагу и увеличить вероятность развития плесени.1. Держите вещи в чистоте и сухости
Плесень питается грязью в волокнах ткани, поэтому не поддавайтесь искушению бросить испачканную одежду обратно в шкаф. Всегда проверяйте, чтобы вещи, только что вышедшие из стирки, полностью высохли, прежде чем повесить их.
2. Держитесь подальше от пластика
Доставайте одежду из мешков для химической чистки как можно скорее. Их полиэтиленовый состав задерживает влагу вокруг волокон, а сырость способствует росту плесени.
3. Поднимите вещи на полу
Переместите вещи, хранящиеся на полу шкафа, на полки. Это сводит к минимуму риск намокания и заплесневения предметов в случае протечки водопровода.
4. Держите двери закрытыми
Этот совет особенно важен, когда погода в Чикаго становится влажной. Держите двери шкафа закрытыми для влажного воздуха и не допускайте влаги, необходимой для роста плесени.
Держите двери шкафа закрытыми для влажного воздуха и не допускайте влаги, необходимой для роста плесени.
Power Tip : Если в вашем доме проблема с влажностью, рассмотрите возможность использования осушителя, специально предназначенного для туалетов.
5. Регулярно чистите туалеты
Сделайте эту работу более чем частью вашей весенней уборки. Каждые несколько месяцев выносите вещи, протирайте полки и запускайте пылесос. Пусть свежий воздух циркулирует в туалете в течение нескольких часов.
6. Не обращайте внимания на затхлый запах
Доверяйте своему носу. Если в туалете пахнет затхлостью и плесенью, покопайтесь, пока не найдете источник. Он может расти за стенами, поэтому рассмотрите возможность привлечения сертифицированного подрядчика по устранению плесени.
7. Разложите пакеты с силикагелем
Когда нас спросят о том, что поглощает влагу в туалетах, мы рекомендуем пакеты с силикагелем. Они очень хорошо контролируют влажность, которая способствует образованию плесени в темных шкафах.
8. Оставьте свет включенным
Плесени нужна влага, чтобы жить, но тепло маломощной лампочки поможет сохранить шкаф сухим. Установите энергосберегающий свет в шкафу и оставьте его включенным 24/7.
Совет по питанию : Убедитесь, что лампа не находится рядом с одеждой или чем-либо еще, что может стать источником пожара.
9. Обменяйте древесину на проволоку
Замените деревянные полки проволочными, чтобы воздух в туалете мог свободно циркулировать. Легкие проволочные полки также более устойчивы к плесени, чем традиционные деревянные стеллажи.
10. Перейдите на двери с жалюзи
Если у вас нет проблем с влажностью в доме, рассмотрите возможность перехода на двери шкафа с жалюзи. Они обеспечивают циркуляцию свежего воздуха, что так важно для предотвращения роста плесени.
Борьба с плесенью в шкафу в Чикаго, штат Иллинойс? Мы можем помочь
Плесень может появиться в самых чистых домах и проникнуть в самые ухоженные шкафы. Вы столкнулись с инвазивным грибком, который быстро распространяется.
Вы столкнулись с инвазивным грибком, который быстро распространяется.
Не рискуйте своим здоровьем, пытаясь избавиться от плесени самостоятельно. ServiceMaster Restoration от Zaba предоставляет сертифицированные в отрасли услуги по удалению и устранению плесени домовладельцам Чикаго, а также мы обслуживаем пригороды. Доступны гибкие варианты планирования, и удовлетворение гарантировано.
Наша команда экспертов по плесени изучит вашу ситуацию с помощью осмотра имущества, высокотехнологичного анализа влажности и сбора образцов. Если плесень обнаружена, команда ServiceMaster by Zaba может начать полное устранение плесени и завершить окончательную проверку, включая анализ проб воздуха, чтобы убедиться, что в вашем доме нет плесени.
Просто позвоните нам, и мы позаботимся о плесени в ваших шкафах: 773-647-1985
Какой вид плесени растет в шкафах?
Та же плесень, которая растет под раковинами и за стенами, также растет и в шкафах.
 Встречается часто. Бояться её не нужно, она быстро удаляется с обоев.
Встречается часто. Бояться её не нужно, она быстро удаляется с обоев. Считается самой опасной из представленных. Стремительно распространяется, выводится трудно. Появиться может везде: кафель, обои, потолок, стены.
Считается самой опасной из представленных. Стремительно распространяется, выводится трудно. Появиться может везде: кафель, обои, потолок, стены. Считается катализатором самых распространённых болезней верхних дыхательных путей: ринит (насморк), ларингит, бронхит, синусит и даже пневмония. При постоянном нахождении в сыром помещении может развиться бронхиальная астма.
Считается катализатором самых распространённых болезней верхних дыхательных путей: ринит (насморк), ларингит, бронхит, синусит и даже пневмония. При постоянном нахождении в сыром помещении может развиться бронхиальная астма. Эта патология опасна сопутствующей симптоматикой. А именно: тошнотой, рвотой, расстройствами кишечника, сильными болями в животе, потерей аппетита. Они же губительно воздействуют на нервную и сердечно-сосудистую системы. Становятся причиной нарушения сна.
Эта патология опасна сопутствующей симптоматикой. А именно: тошнотой, рвотой, расстройствами кишечника, сильными болями в животе, потерей аппетита. Они же губительно воздействуют на нервную и сердечно-сосудистую системы. Становятся причиной нарушения сна. Это нужно обязательно сделать, потому что под ними могут находиться споры, которые потом спровоцируют новую вспышку заражения.
Это нужно обязательно сделать, потому что под ними могут находиться споры, которые потом спровоцируют новую вспышку заражения.
 Перед очисткой тщательно просушить строительным феном или бытовым обогревателем.
Перед очисткой тщательно просушить строительным феном или бытовым обогревателем.

 Работайте в специальной одежде и проветривайте помещение, чтобы как можно быстрее завершить процесс решения проблемы, как вывести плесень на стенах. Дети и беременные женщины не должны находиться в помещении в течение недели.
Работайте в специальной одежде и проветривайте помещение, чтобы как можно быстрее завершить процесс решения проблемы, как вывести плесень на стенах. Дети и беременные женщины не должны находиться в помещении в течение недели.  Перед использованием любого из следующих инструментов необходимо провести работы по очистке. Оформите его, придерживаясь четко такой схемы:
Перед использованием любого из следующих инструментов необходимо провести работы по очистке. Оформите его, придерживаясь четко такой схемы: 


